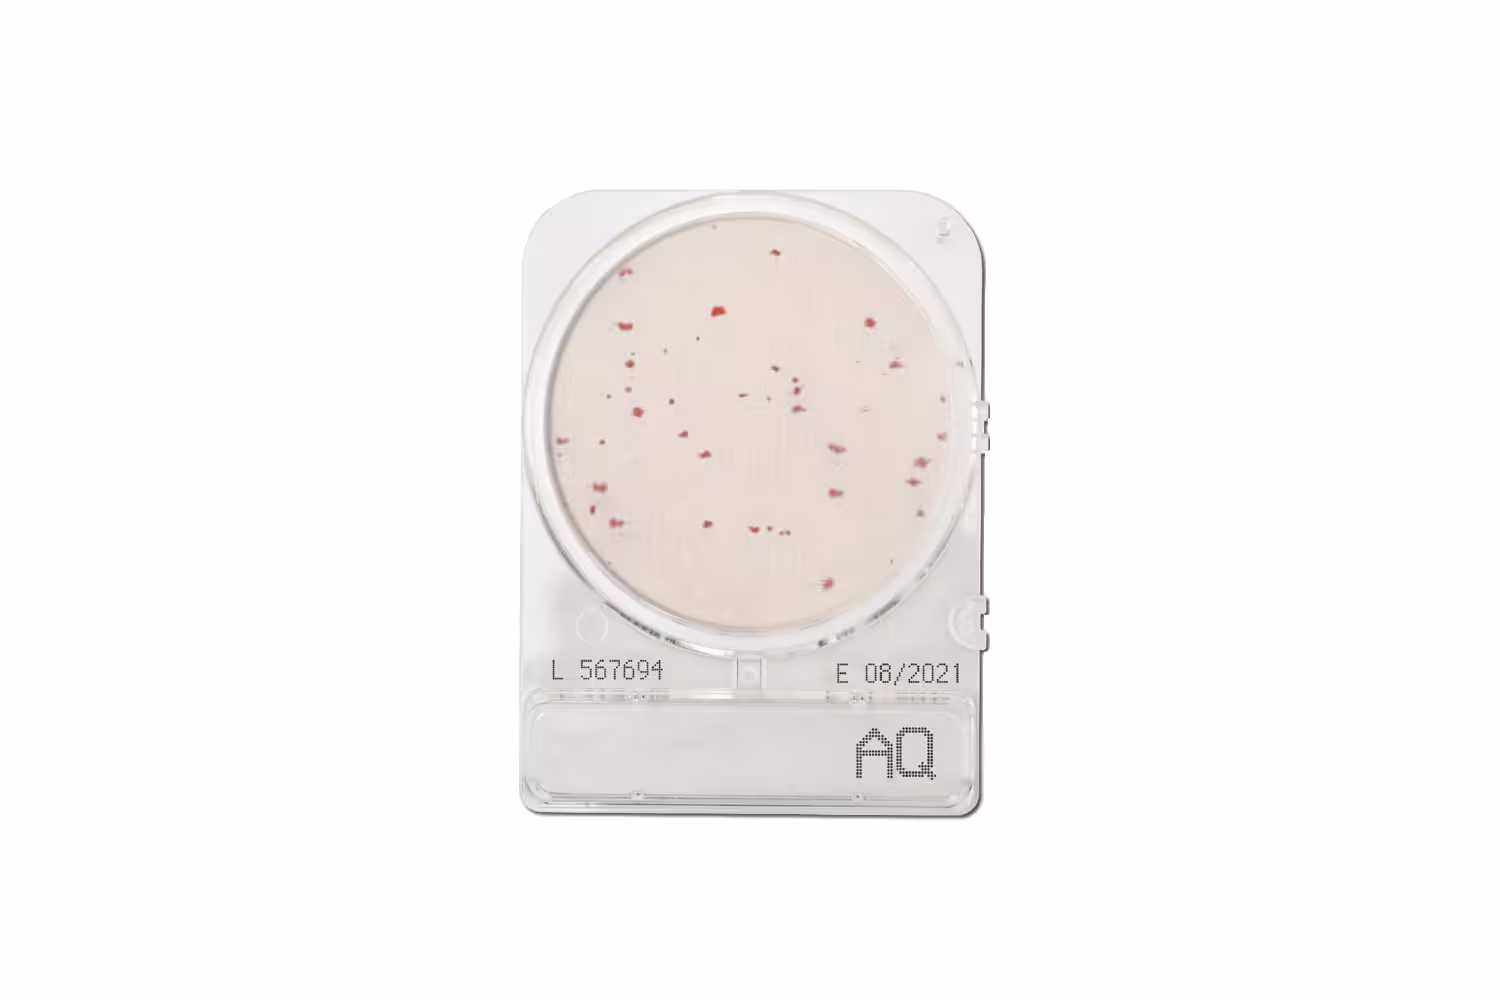
Compact Dry AQ Compact Dry AQ
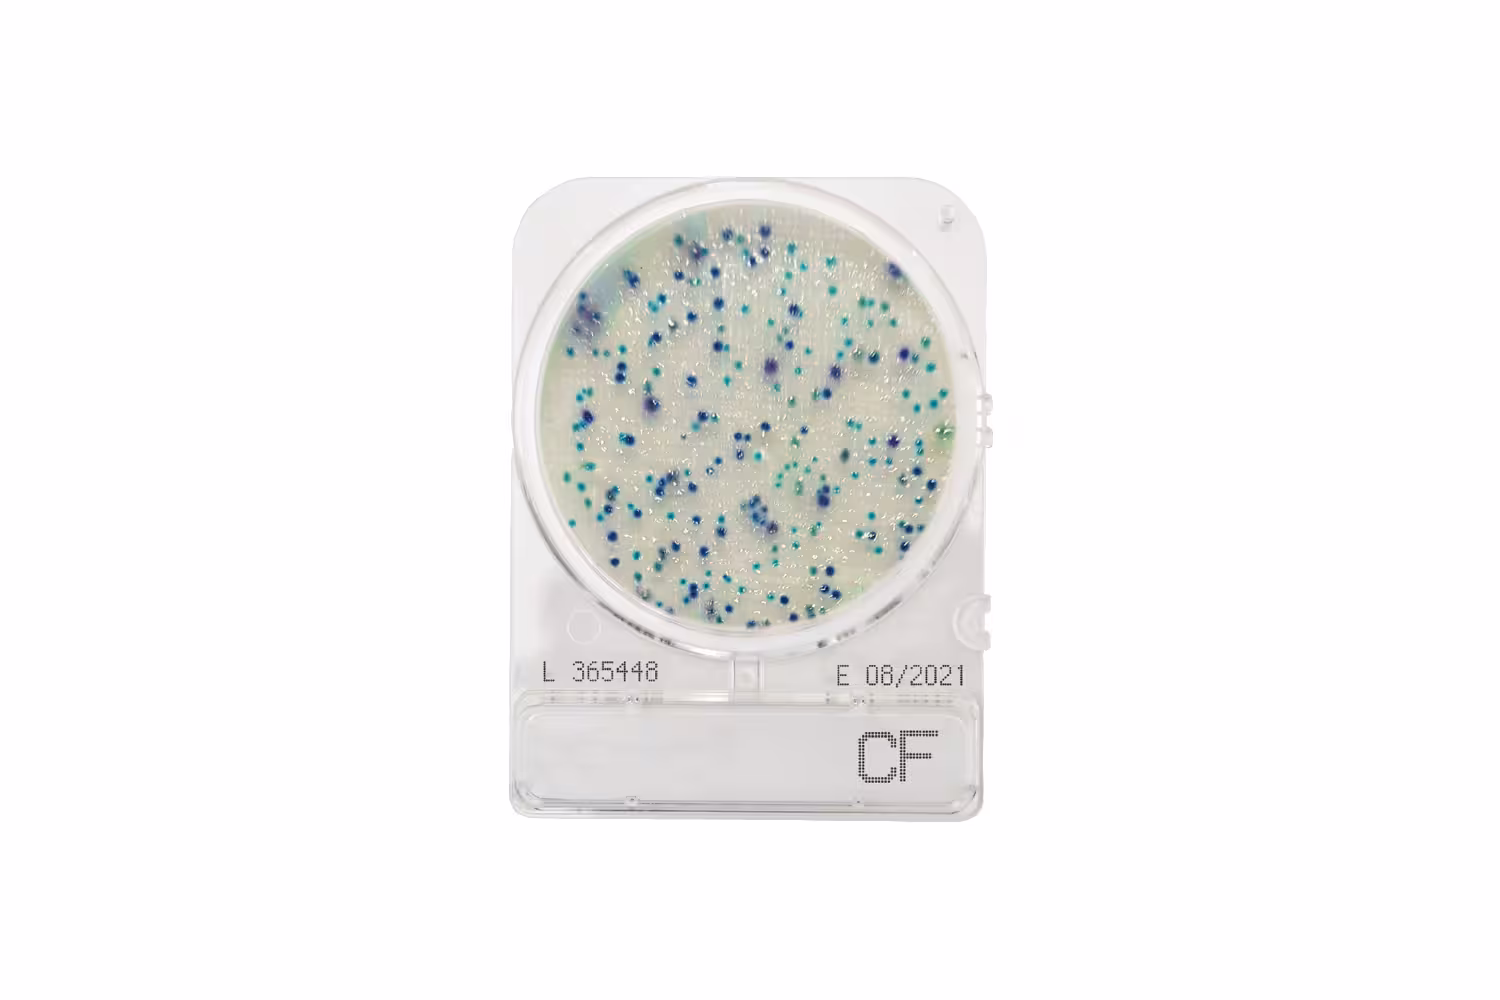
Compact Dry CF Compact Dry CF

Compact Dry™ plates provide a convenient test method for counting micro-organisms. The plates are supplied sterile and ready-to-use, and the media are dehydrated allowing for a long shelf life at room temperature. The incorporation of chromogenic agents in the media ensures that the plates are easy to interpret, making them an ideal alternative to the conventional culture plate method.
The plates can be used to test raw materials and finished products such as food, beverages, meat and cosmetics. Compact Dry™ is ideal for laboratory use and is portable, facilitating on-site sampling.